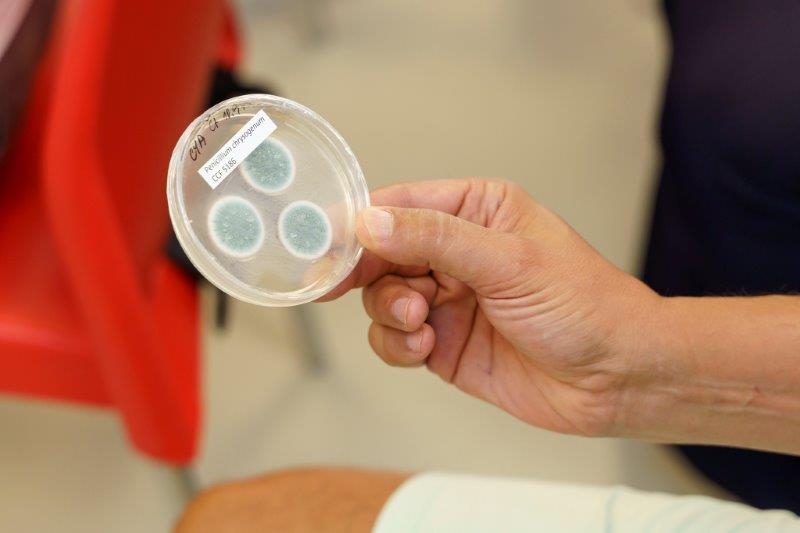
TK VEKRA Baumit Bydlete zdravě 15. 9. 2020 5 1

Bydlíte opravdu zdravě? Přesně tuto otázku jsme položili hned 40 novinářům a jejich čtenářům, kteří se přišli i v divoké době koronavirové podívat na naši tiskovou konferenci. Ovšem ani ti, kteří se nemohli dostavit osobně, nebyli o zážitek ochuzeni. Celou konferenci totiž sledovali online v přímém přenosu. Hostiteli akce byli dva přední hráči na českém stavebním trhu, kterým zdravé bydlení rozhodně není lhostejné – VEKRA a Baumit. Odborníci z Baumitu nám představili svoje unikátní omítkové systémy, které dokážou přispívat ke zlepšení kvality vnitřního ovzduší. VEKRA pak rovnou v praxi předvedla, že pro bydlení ve zdravém prostředí je důležitá i správná montáž oken. Pozvala si na to svého dlouholetého zaměstnance, montážníka Jardu a zasloužilého řemeslníka Pepu. Oba pánové pak přímo na místě zabudovali dvě identická okna do připravených otvorů. Novináři pak na obou oknech na první pohled nenašli žádný rozdíl, ale jedno z nich v sobě přitom do budoucna skrývalo potenciální biologickou bombu… Že celá akce sklidila úspěch, pak potvrdila i pozitivní reference na akci v magazínu Prosperita (k přečtení ZDE).